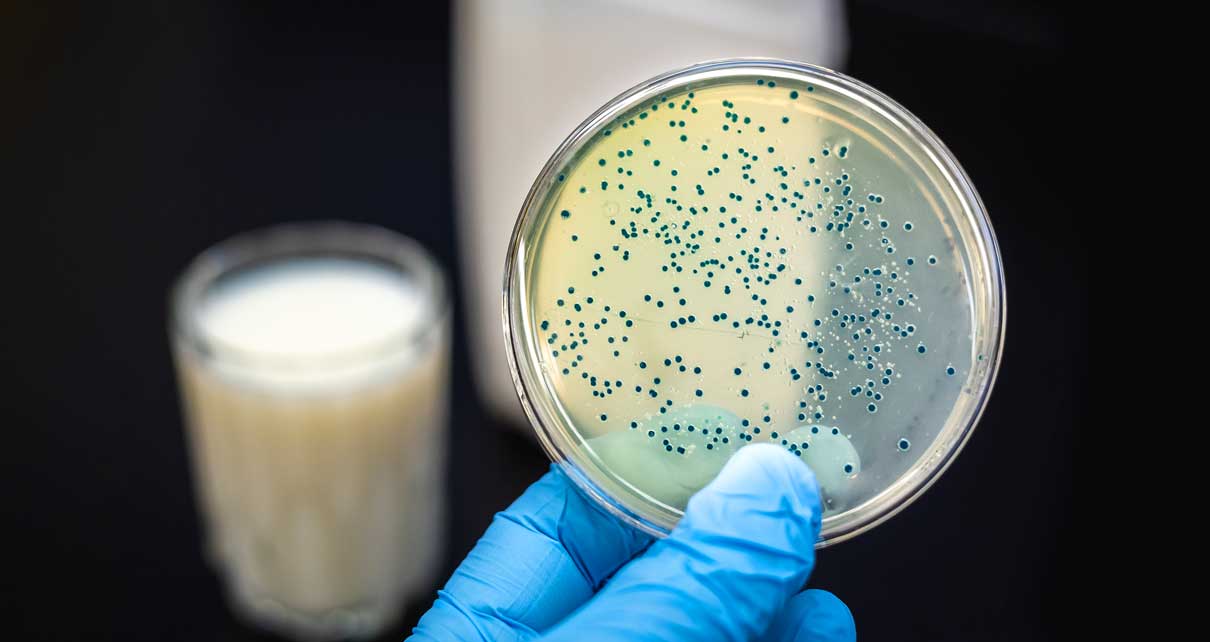

El bienestar intestinal ya no es una tendencia: es un terreno de diferenciación entre quienes prometen salud y quienes la demuestran. La nueva generación de prebióticos invisibles —inulina, dextrinas resistentes, fructanos de agave— trabaja sin alterar el sabor ni la textura, pero agrega valor real.
Son ingredientes que no se ven, pero rediseñan la percepción de “naturalidad inteligente” en el anaquel.
Las bebidas prebióticas, yogures funcionales y gummies con fibra soluble están desplazando el viejo discurso de “alto en fibra” hacia narrativas más sensoriales y aspiracionales: “salud desde adentro”, “balance intestinal” o “energía limpia”.
En paralelo, los postbióticos están ganando terreno porque ofrecen los beneficios de los probióticos sin los riesgos de viabilidad. Son aliados perfectos para matrices RTD, snacks o productos horneados que requieren estabilidad térmica.
En este nuevo escenario, la confianza es la moneda. Las marcas que comuniquen dosis reales, evidencia científica y claims moderados —sin exagerar efectos— serán las que sobrevivan a la próxima ola regulatoria.
La salud digestiva se está tecnificando, y los consumidores lo saben. La frontera entre ciencia y marketing se ha vuelto difusa, pero también más exigente.